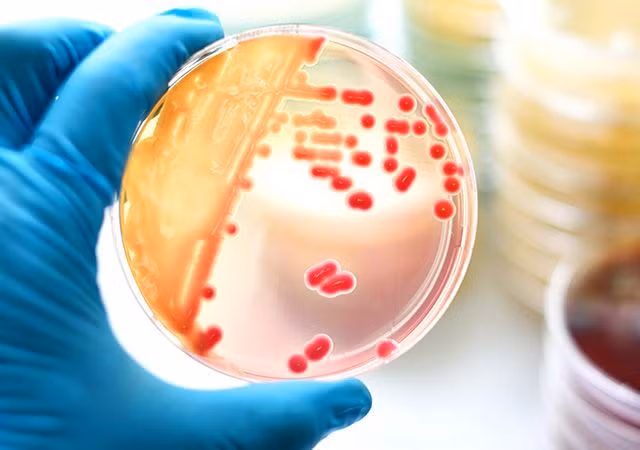
Co gai 17 tuoi cap cuu vi an thit nuong, chuyen gia chi ra 4 dieu cam ky

Tiểu Triệu, 17 tuổi, ở Hàng Châu, Trung Quốc, vào cuối tháng trước, cô bé bắt đầu có triệu chứng đau đầu, ho và sốt. Cô nghĩ đó chỉ là một cơn cảm lạnh thông thường. Sau khi mua một số loại thuốc cảm lạnh ở hiệu thuốc, Tiểu Triệu về nhà uống thuốc và nghỉ ngơi.
Vào sáng sớm một ngày trước khi nhập viện, Tiểu Triệu đang đi trên đường thì đột nhiên bị ngất xỉu. Khi có người phát hiện, Tiểu Triệu bị hôn mê bất tỉnh và đang nằm trên vệ đường, cuối cùng cô được người dân giúp đỡ đưa vào bệnh viện.
![]() |
| Tiểu Triệu bị nhiễm loại vi khuẩn kỵ khí Fusobacterium necrophorum |
Từ phòng cấp cứu, các bác sĩ kiểm tra cho Tiểu Triệu và phát hiện: nhiệt độ cơ thể 40,6 ° C, nhịp tim 157 nhịp/phút, 72/50 mm Hg. Các bác sĩ nhận thấy chức năng tim, gan, thận của Tiểu Triệu bị suy giảm, chỉ số nhiễm trùng rất cao, CT ngực cho thấy hai phổi có một khu vực lớn bị viêm, tình trạng bệnh rất nghiêm trọng.
Sau khi kiểm tra kỹ lưỡng, bác sĩ phát hiện ra Tiểu Triệu bị nhiễm một loại vi khuẩn rất hiếm thấy trên lâm sàng - Fusobacterium necrophorum. Đây là một loại vi khuẩn kỵ khí thường được tìm thấy ở một số động vật và con người hiếm khi bị nhiễm bệnh.
Vi khuẩn gây bệnh liên quan đến thịt nướng bẩn
Tiểu Triệu cho biết, cô đã ăn thịt nướng trong một quán bên đường trước khi phát bệnh. Kết hợp xét nghiệm di truyền và kết quả cấy máu trong bệnh viện cho thấy bệnh của Tiểu Triệu có khả năng là do ăn một số thịt không hợp vệ sinh và chưa được nướng chín, mới dẫn đến nhiễm trùng.
![]() |
| Thịt nướng không hợp vệ sinh và thịt chưa chín là thủ phạm gây bệnh của Tiểu Triệu |
Các loại thịt nướng là "món tủ" của rất nhiều người, tuy nhiên một điều khẳng định rằng thịt nướng không vệ sinh rất có hại cho sức khỏe. Khi các loại thịt được ướp gia vị nướng trên lửa sẽ sản sinh ra các chất gây ung thư như amin dị vòng, benzopyrene. Ngoài ra, nếu ăn thịt nướng chưa chín, rất dễ bị nhiễm các loại vi khuẩn đe dọa sức khỏe.
4 điều cấm kỵ khi ăn thịt nướng
1. Ăn thịt nướng tái
Nhiều người không thích ăn thịt nướng quá chín, cho rằng thịt sẽ dai và mất hương vị của thịt, do vậy thích ăn thịt chín tái. Điều này rất nguy hiểm, ăn thịt tái rất dễ bị nhiễm ký sinh trùng, đồng thời còn tiểm ẩn nhiều nguy hiểm cho sức khỏe.
2. Ướp quá nhiều gia vị khi nướng thịt
Ướp quá nhiều gia vị, các loại nước sốt vào thịt nướng, không những khiến thịt dễ cháy còn làm tăng lượng muối vào cơ thể. Vì vậy tốt nhất hãy pha nước sốt riêng để chấm thịt, đồng thời còn làm giảm việc sản sinh các chất gây ung thư.
3. Ăn thịt nướng mà không ăn rau
Bọc thịt nướng với rau lá xanh có thể làm giảm đáng kể độc tính của chất gây ung thư. Cũng có thể ăn kèm thịt nướng với các loại salad rau củ.
4. Ăn thịt nướng quá nóng
Hãy nhớ rằng ăn thức ăn quá nóng sẽ không chỉ làm hỏng màng nhầy trong thực quản mà còn gây bỏng ở miệng, đồng thời kích thích tăng sản niêm mạc, để lại sẹo và viêm. Một số chuyên gia tin rằng sự xuất hiện của một số bệnh ung thư thực quản có thể liên quan trực tiếp đến thức ăn nóng.